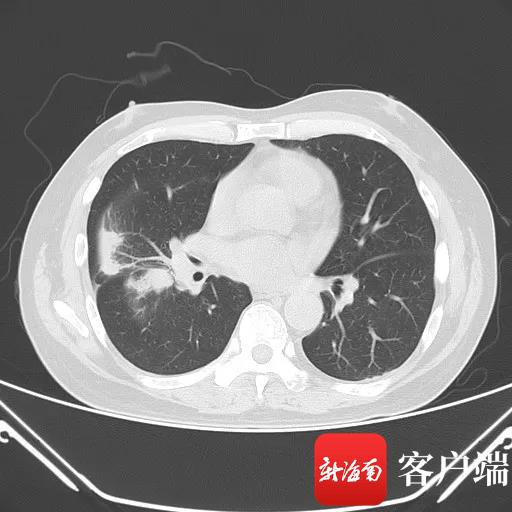
博鳌乐城抗癌新药,博鳌新药瑞普替尼

新海南客户端、南海网、南国都市报10月11日消息(记者 苏桂除 通讯员 张晨曦)“非常感谢乐城先行区,感谢博鳌恒大国际医院的医护人员,让我的病情得到有效控制。”近日,博鳌恒大国际医院一位62岁肺癌患者,带着国际新药劳拉替尼高兴地出院了。早在2年前,李先生还在国内外四处寻医问药,最终在乐城找到了续写生命的有效药。
2018年10月,李先生被确诊为右肺非小细胞型腺癌IV期,2019年1月,李先生转至英国治疗,局部疼痛症状有所缓解。医院基因检测判断认为,李先生的症状属于ALK阳性的非小细胞肺癌,又选择回到国内医院服用阿来替尼进行治疗,病情一度好转。2020年6月复查后,医生判断,李先生对阿来替尼耐药,病情再一次失控。
患者李先生右肺下叶肿瘤。
非小细胞肺癌约占所有肺癌的80%,约75%的患者发现时已处于中晚期,5年生存率很低。李先生所患的ALK阳性的非小细胞肺癌,发现时也是晚期,又对其他药物产生耐药,急需新的药物来延长患者生存期。
因新冠肺炎疫情无法出国,李先生又几经辗转、四处咨询,从一位专家那里了解到海南博鳌乐城国际医疗旅游先行区内的博鳌恒大国际医院有专家治疗,而且乐城先行区有特许医疗政策,还有国外上市、国内未上市的国际新药用于治疗。
2020年8月,李先生来到博鳌恒大国际医院肿瘤内科就诊,该医院肿瘤内科主任叶刚教授专家团队对其病史及检测报告全面分析,并与美国布莱根和妇女医院-丹娜法伯癌症中心专家团队进行了国际远程会诊,并确定诊疗方案。

国际新药劳拉替尼。
据了解,国外先进创新药物及医疗器械进入国内市场,至少需要5年左右的时间,而依托乐城先行区“特许医疗”政策,乐城先行区的博鳌恒大国际医院可以从境外直接引进国外已上市、国内未上市的国际新药。
叶刚表示,目前,李先生所用的第三代治疗ALK阳性非小细胞肺癌药物劳拉替尼,它是专门为克服一代或二代ALK靶向药的耐药而设计生产的,已有临床试验的证据表明其对一代或二代靶向药耐药的患者仍能有效且显著延长病情无进展时间,因而已得到美国及欧洲药监部门的批准,这款药物并未在国内上市,但依托乐城先行区“特许医疗,先行先试”的政策优势,我们可以直接引进这款国际新药,在国内率先使用,并可申请特许口服药物带离园区服用。
在李先生住院前,医生提前了解并全面评估他的病情,分析他适用此药物做治疗后,医院立即启动引进此药物,并从美国空运至上海后转运到博鳌公共保税药仓,可以说药物运输流程很顺畅。医院也会同步整理药品相关资料提交至特许药械追溯系统,在经过海南省卫生健康委员会和海南省药品监督管理局等部门的层层把关及审批后,患者即可使用此药物进行治疗。
李先生在院治疗期间,肿瘤内科医生全程指导他规范服用劳拉替尼,时刻观察用药后的反应,在服用一周后,李先生全身骨痛明显缓解,也未出现明显的副反应。
叶刚说:“面对创新药物,医生和患者都需警惕,保障患者的用药安全。患者带药离院后,不能不管不顾自行服用,要有专业医生监管指导患者合理用药。一旦出现副反应能够及时处理。”
乐城先行区作为全国唯一的“医疗特区”,有国家赋予的先行先试政策优势。希望第三代治疗ALK阳性非小细胞肺癌药物劳拉替尼能够作为乐城先行区先行先试的一个重要典范,为先行先试政策积累更多的经验,同时在博鳌恒大国际医院进行相关的医疗工作,也将造福更多的中国患者。